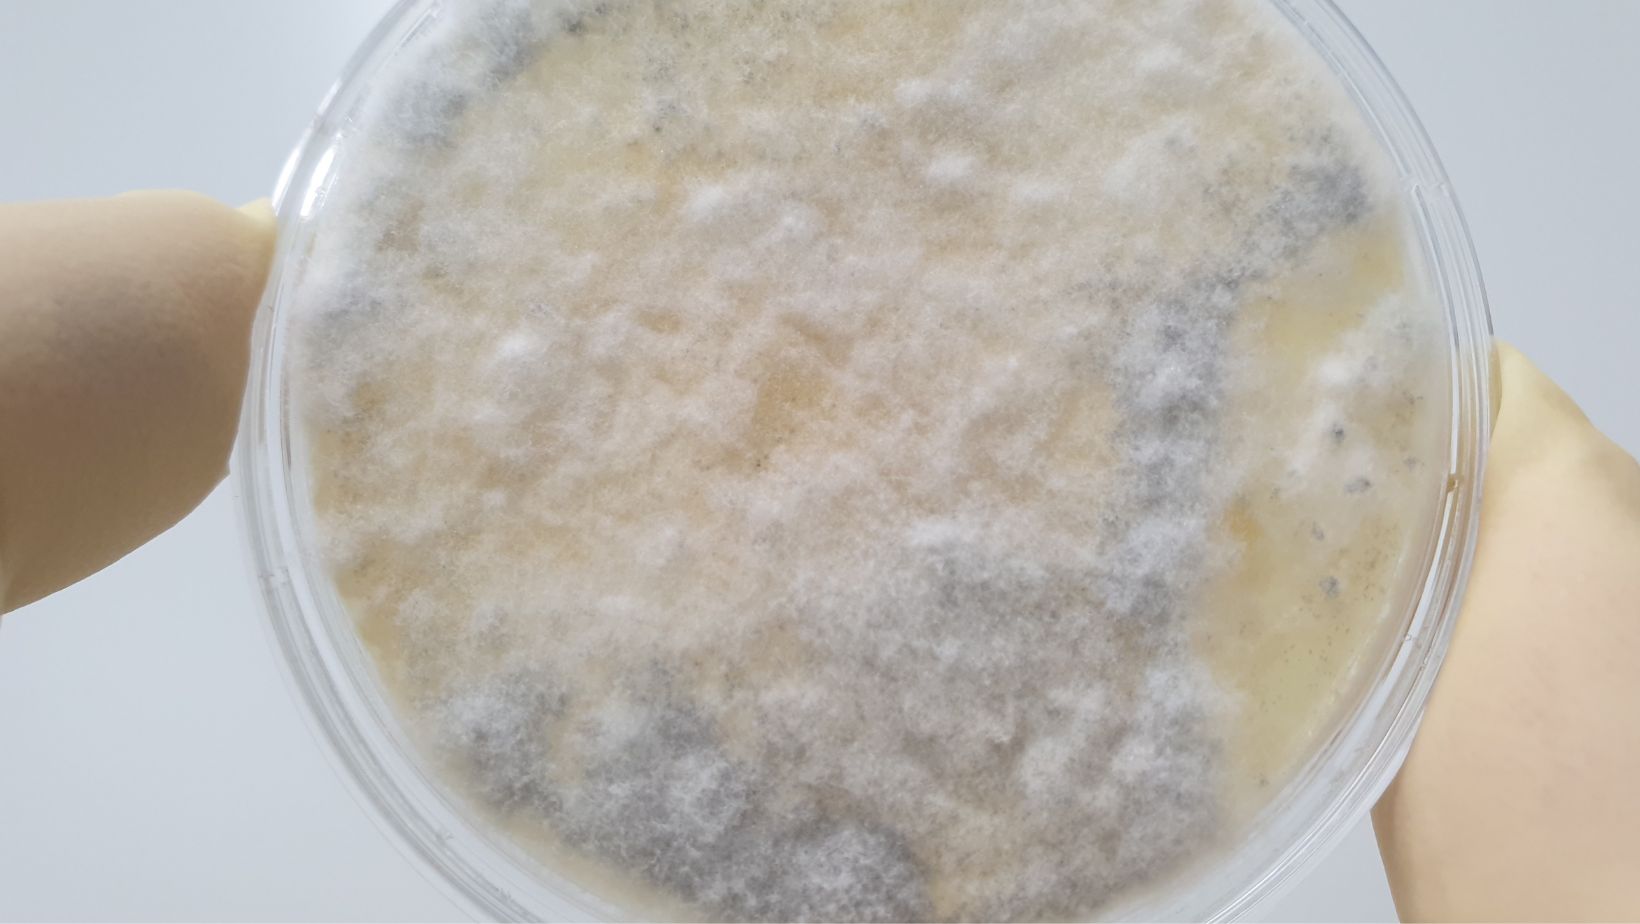

Mikrobiell påväxt/ Mikrobiell lukt
I besiktningsprotokoll nämns ofta mikrobiell påväxt eller mikrobiell lukt. Detta skapar frågor som: Vad innebär det? Bör jag vara orolig? Kan det bli dyrt?
Vad är mikrobiell påväxt?
Mikrobiell påväxt innebär att det växer någon form av mikroorganismer, vilket kan vara synligt för blotta ögat. I denna kategori ingår bakterier, mögel, röta, blånadssvamp, alger och andra mycket små organismer. I vissa fall räknas även virus till mikroorganismer, även om dessa är så små att de inte går att se utan mikroskop.
Om mikrobiell påväxt finns i ett hus, exempelvis på vinden eller i krypgrunden, kan man ofta se tecken på att något växer där, eller i vissa fall känna en mikrobiell lukt, som är ett tecken på påväxt.
Mögel är en vanlig form av mikrobiell påväxt som ofta syns som svarta eller grå fläckar på ytor. En mikrobiell påväxt är ett tydligt tecken på att huset är för fuktigt och att det förekommer en stor mängd mikroorganismer som kan påverka både byggnadens struktur och inomhusklimatet. Det är viktigt att åtgärda mikrobiell påväxt snabbt för att förhindra skador och hälsorisker.
» Till luftrenare
Är mikrobiell påväxt farligt?
Det är inte all form av mikrobiell påväxt som är farlig, De mest aggressiva svamparna kan äta upp ett hus på några år. Beroende på vad det är som växer kan mikroberna avge giftiga mykotoxiner och skadliga mögelgifter som man inte bör utsätta varken djur eller människor för.
Varifrån kommer mikroorganismerna?
Enkelt förklarat så finns mikroorganismer överallt; luften innehåller alltid mikroorganismer och mögelsporer. Men det är förutsättningarna i huset som avgör om de får fäste och börjar växa till i huset. Generellt vill mikroorganismerna ha en tillräckligt hög temperatur, tillgång till näring och fukt för att växa. Exakt vad som krävs skiljer mellan olika typer av mikroorganismer.
Vanligtvis är de flesta förutsättningarna uppfyllda i huset med undantag för fukten. Det är därför det är så viktigt att hålla borta fukt från huset, eftersom tillräckligt med fukt snabbt kan ge mikrobiella angrepp. Tyvärr, är det även vanligt med för höga fuktnivåer i våra hus.
Varför förekommer mikrobiell påväxt i huset?
Mikrobiell påväxt finns i hus som är för fuktiga – vilket betyder att någon form av avfuktning är nödvändig. Olika typer av mögel, röta, blånad m.m. växer vid olika förutsättningar. Ofta finns flera av de här förutsättningarna tillgängliga i huset och frön (svampsporer) finns överallt. Den lättaste förutsättningen att kontrollera är fukten, eftersom de olika svamparna inte växer om det är tillräckligt torrt.
Konsekvenser av mikrobiell påväxt
En mikrobiell påväxt behöver inte vara farlig eller dyr att åtgärda. Konsekvenserna beror på vad det är för typ av påväxt och hur omfattande den är. Röta försvagar exempelvis husets konstruktion i och med att det kraftigt bryter ned trä, och mögel producerar gifter, som i många fall påverkar människors hälsa.
» Läs mer om Mikrobiell påväxt i vårt fuktlexikon
Vad är mikrobiell lukt?
Mikrobiell lukt är den odör som bildas av bakterier, mögel eller röta och kan orsaka en luktsmitta i ett hus. Mögelsvampar utsöndrar mögelgifter, eller mykotoxiner, som är skadliga att andas in för både människor och djur. Därför skall man aldrig tolerera mikrobiell lukt i en huskonstruktion.
Svårt att bli av med mikrobiell lukt
Material som utsätts för mikrobiell lukt kan drabbas av luktsmitta. Luktsmitta kan drabba kläder, textilier, stoppade möbler, tapeter och andra material i hemmet. I vissa fall kan man tvätta materialen, men i andra fall är detta svårt. Man kan bli tvungen att byta ut drabbade material och renovera för att bli av med den mikrobiella lukten.
Mikrobiell påväxt/Mikrobiell lukt i besiktningsprotokollet
Alla typer av mikrobiell påväxt är inte farliga, men om det förekommer vid ett husköp bör man som köpare kräva både sanering och en aktiv åtgärd från säljaren. Att mikrobiell påväxt förekommer i huset, är ett tecken på att huset är för fuktigt, och detta måste åtgärdas, för att undvika värre problem. Om mikrobiell påväxt förekommer i huset skall det skrivas in i besiktningsprotokollet och det är därför viktigt att du som köpare verkligen anlitar en kunnig besiktningsman.
Åtgärder mot mikrobiell påväxt/mikrobiell lukt
Mikrobiell påväxt tyder på att fuktnivåerna är för höga i utrymmet. Om det är mycket lite mikrobiell påväxt kan det räcka med att åtgärda problemet med höga fuktnivåer. Det är dock viktigt att veta att det inte förekommer en försvagning av konstruktionen eller att skadliga partiklar kan ta sig in i boytan.
Vanligtvis minskar man fuktnivåerna med en avfuktare. En avancerad avfuktare, som Trygghetsvakten, mäter flera olika parametrar och anpassar insatserna därefter. Vissa varianter av Trygghetsvakten ventilerar även utrymmet och skyddar på så vis boytan från skadliga partiklar och obehaglig lukt. Om fukten beror på läckage eller dålig dränering, ska naturligtvis detta åtgärdas. Du bör också ha marktäckning i krypgrunden, för att skydda mot fukt från marken.
Om den mikrobiella påväxten är något större, krävs sanering och här rekommenderar vi att du vänder dig till en expert eftersom både mögel och saneringsvätskor kan vara mycket giftiga. När den mikrobiella påväxten har sanerats, måste man ändra förutsättningarna så angrepp inte uppstår igen. Vanligtvis gör man detta genom att installera en avfuktare.
» Läs mer om att mäta fukt i hus och villor